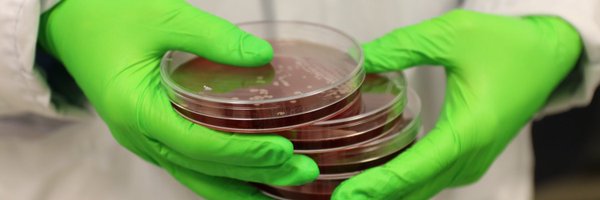
BergstenHelena Profile Banner
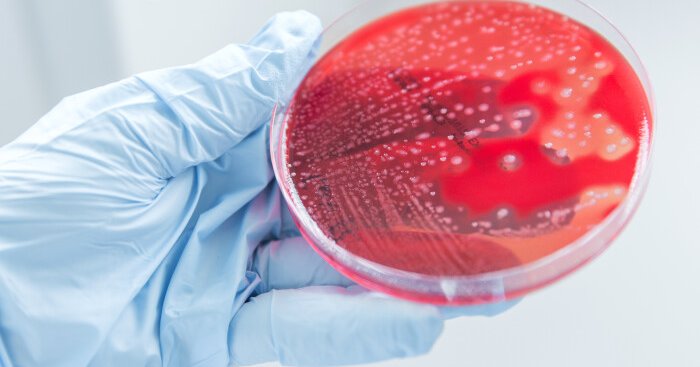
Tweet card summary image

Helena Bergsten
@BergstenHelena
Followers
346
Following
2K
Media
76
Statuses
320
MD, PhD • Postdoctoral researcher at University of California San Diego in the lab of Victor Nizet • Treatment options in infections by S. pyogenes & S. aureus.
Stockholm, Sverige
Joined November 2017
Immunity to #StrepA is complex! 🧫🤒Pharyngitis elicits serum IgG and muted mucosal IgA. Pre-existing antibodies inversely correlated with the magnitude of IgG induced. Great work @JoshOsowicki et al!
nature.com
Nature Communications - Streptococcus pyogenes is a deadly bacteria without a vaccine. Here, researchers measured antibodies in serum and saliva from a strep throat human challenge trial. Baseline...
This #StrepA paper was a LONG labour of love from a great team 😊 Equal first & senior author credits buried at the very end, so I want to highlight the critical contributions of @hrcfrost @njmoreland & @DrDanikaHill (see her great thread on 🦋)
1
0
3
The intricate pathogenicity of Group A Streptococcus: A comprehensive update - out now in @Virulence12 by @victornizet and I 🧫 Updates: airborne transmission, lymphatic spread & neuronal interactions. Inflammation, necrosis & immune evasion. iGAS focus. https://t.co/Ydgiq0AI2o
1
5
25
New from @BergstenHelena in @Virulence12 Journal: "The intricate pathogenicity of group A Streptococcus: A comprehensive update" Full article link: https://t.co/hg01KtnX5d
0
9
37
🤨🦠Did you say IgM?!? Very proud that this publication is now officially online. Post-doc work from the dedicated and talented 💪 Astrid Hendriks. Collaborative effort also showcasing importance of clinical cohorts. Hope you enjoy it! https://t.co/OOxv9okRra
1
11
35
🔥❤️🔥🔥❤️🔥 @LancefieldSoc_ #LISSSD25 in Brisbane. Get in line (in pairs or chains) and get moving on your abstracts (submission site open NOW). Can't wait to see you there 😀 https://t.co/WZSH8dH2Gi
1
7
12
asian seafood buffet 🍣🍜🥟🍱 farewell celebration for two great physician scientists as their extended sabbatical fellowships in the lab draw to a close —@BergstenHelena 🇸🇪 + Chih-Ho Chen 🇹🇼 — best wishes in your ongoing careers in infectious diseases care and research!
0
2
8
A phage lysin that battles MRSA in the nasal cavity has reached the first clinical trial phase in Germany. https://t.co/g9yyMhjiPu
@DZIF_ @uni_greifswald @TU_Muenchen
the-microbiologist.com
HYpharm's innovative preventive agent HY-133 has reached the first clinical trial phase. HY-133 is specifically effective against Staphylococcus aureus including multi-resistant strains and is...
0
14
25
The biggest congratulations to our Jenny @MjosbergL for her efforts in fighting severe asthma, now awarded the grand research grant of the Heart-Lung Foundation for her groundbreaking work. Read more about it here: https://t.co/Kyz6Cumtzp
news.ki.se
Some 40,000 Swedes live with severe asthma, a disease that causes considerable suffering. Thanks to grants from the Swedish Heart-Lung Foundation, KI researcher Jenny Mjösberg has discovered a...
0
1
6
Congratulations to @SD_IRACDA Postdoctoral Scholar Alex Hoffman, PhD on her new review in @JPET_Journal describing the novel application of human membrane-coated nanomedicines to treat sepsis, pneumonia, and other life-threatening bacterial infections. https://t.co/u9UB0zxI5Y
1
3
24
Fascinating study. Provocative findings. Are we using too much pip-tazo? And I still don’t get why we use so much anti-pseudomonal agents for empiric sepsis
Most patients with sepsis don't need anti-anaerobic antibiotics. But most get them anyway. Why not, what's the harm? I worry the harm is considerable. Our new study in @JAMAInternalMed: using a 15-month pip-tazo shortage to answer this question. 1/n https://t.co/1nOhsUaio0
9
21
90
🔥 🚨 🔥 SAVE THE DATE 🚨 🔥 🚨 @LancefieldSoc_ inaugural EMCR network webinar just around the corner! Sorry for the late notice. Don’t miss the legendary @AnnaTeglund! Registration details coming very soon! Please retweet and spread the good news 😊
1
12
19
How does a monocyte become a macrophage? We found intestinal stromal cells guide macrophage differentiation via GM-CSF in human gut! Now out @NatureComms @karolinskainst
https://t.co/P9Njuz1OXT
20
93
404
Proud @UCSanDiego to help launch this interdisciplinary @FondationLeducq initiative to understand Strep A immunity, improve treatments, and guide a future vaccine to prevent strep throat, invasive infections, and rheumatic heart disease /1
imperial.ac.uk
Imperial and US scientists are spearheading a multi-institution network to research bacterial cause of sepsis and heart damage in children.
1
6
20
Ökat antal fall med invasiva grupp A-streptokocker
folkhalsomyndigheten.se
Ny sammanställd statistik visar att antalet rapporterade fall med invasiva grupp A-streptokocker, iGAS, ökade till cirka 1300 under år 2023. Sjukdomsförloppet kan vara hastigt, och det är viktigt med...
0
2
4
Viruses are transmitted via aerosol. Likewise for bacteria. The odds of this depend on many factors, including how long the bacteria remains viable in air. Our latest work studies the aerostability of Group A Strep, and WHY does it lose viability in air:
microbiologyresearch.org
5
47
130
Off to a good start of 2024! Our comparison of meningitis causing Group A Streptococcus strains with otitis and colonizing strains revealed no distinct invasive pheno- or genotype, indicating continous spread of the infection. @microbiologyOA
https://t.co/h6tc3ObgMZ
onlinelibrary.wiley.com
Group A streptococcal (GAS) meningitis causes high morbidity and mortality. To elucidate the invasiveness of GAS in meningitis, we compared five GAS meningitis isolates to otitis and colonizing...
0
3
14
Are you a #postdoc interested in #immunology and how our immune system reacts to #enterovirus infection and #vaccination? Want to help find a prevention for #T1D? This could be an opportunity for you: https://t.co/02312Nwpf0
#postdocjobs @MFT_Diabetes @CIM_Sweden @karolinskainst
ki.varbi.com
Vill du bidra till medicinsk forskning av toppkvalitet? I vår forskargrupp finner du en unik möjlighet att arbeta tätt tillsammans med andra forskare för att förstå hur kroppen svarar på virusi
1
18
25
The Baker Lab at Oregon Health & Science University is hiring, both postdocs and research assistants. DM me if you know someone who is interested in learning to apply ‘omics and molecular biology to learn how the #micriobiome impacts our health. #microbiology
#bioinformatics
12
78
216
Honored to be inducted tonight into @theNAMedicine in Washington DC — all the credit to my supportive family who shared in the festivities and to all my lab members and collaborators @UCSanDiego whose contributions the award truly recognizes.
28
12
142